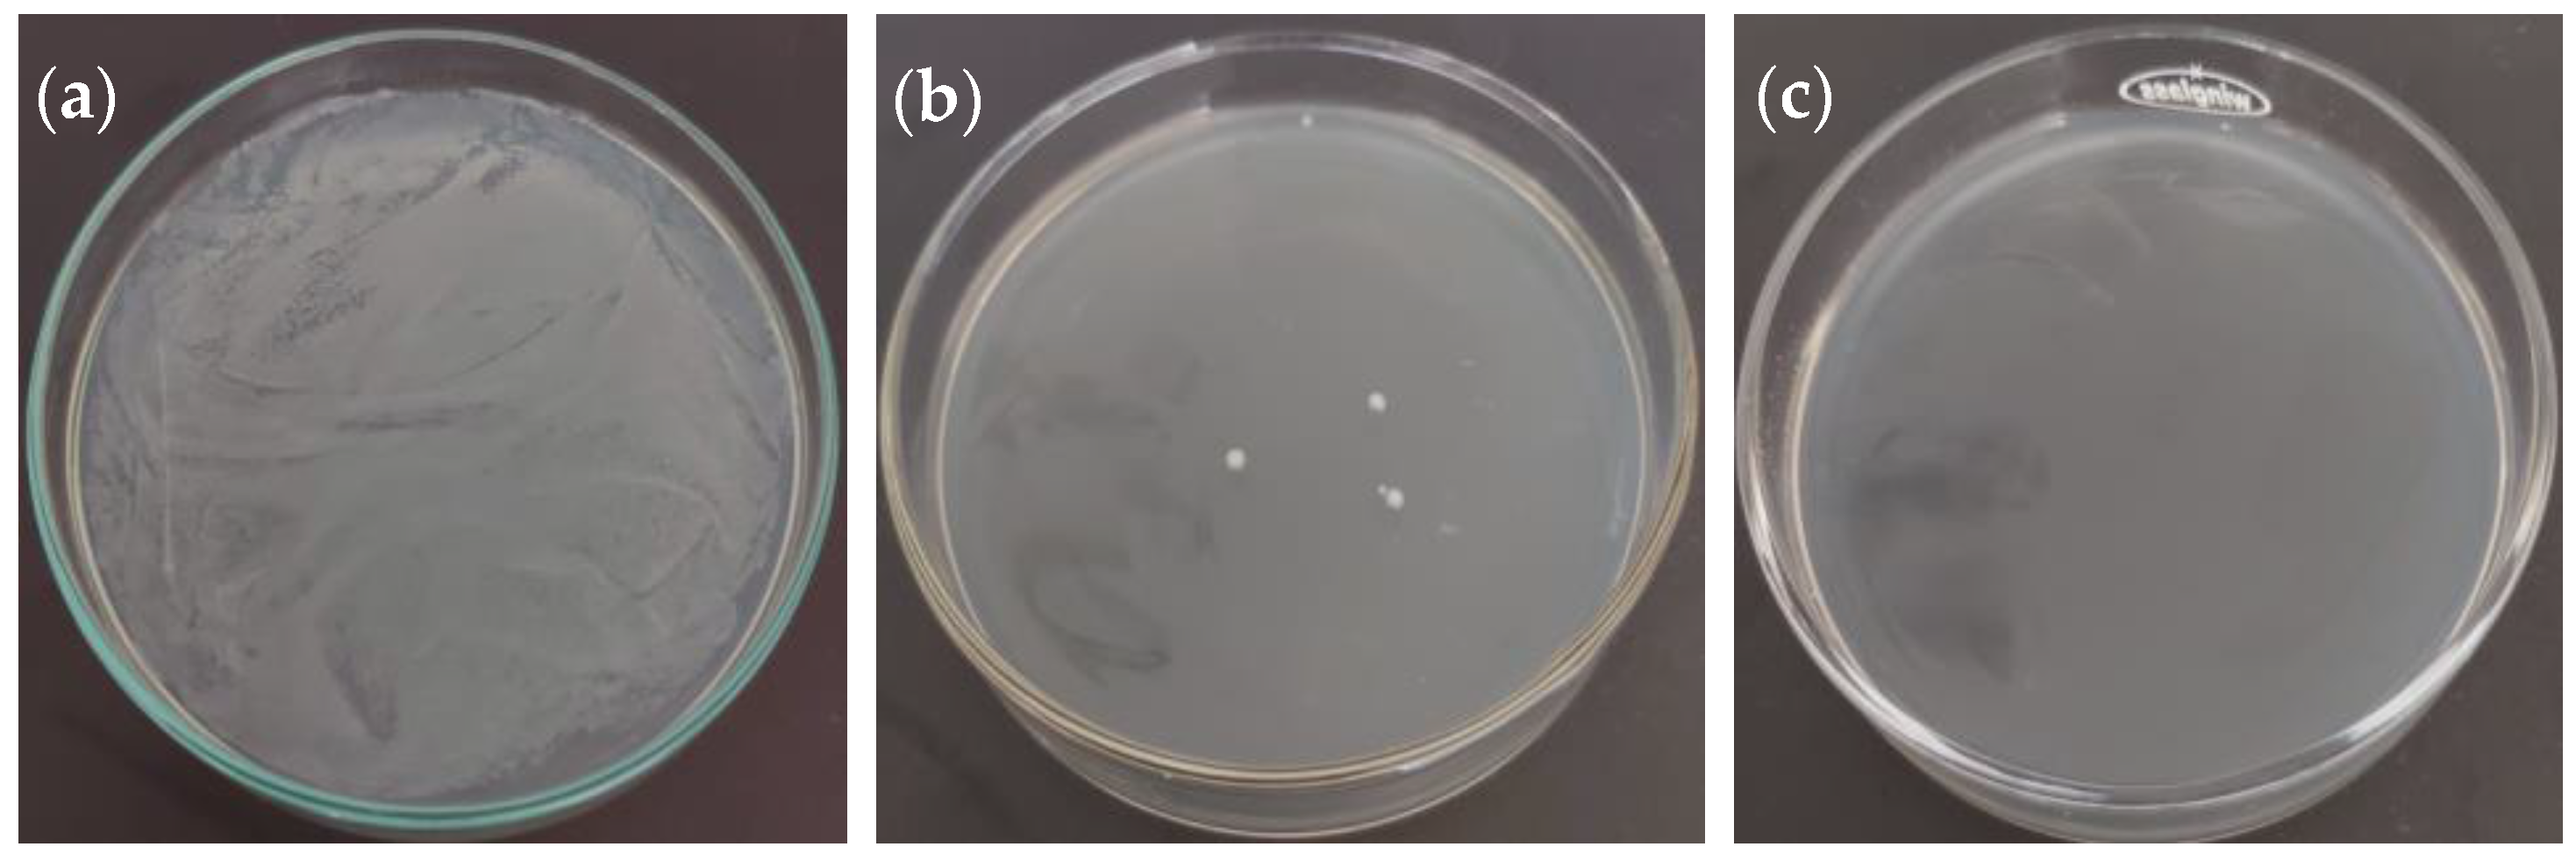
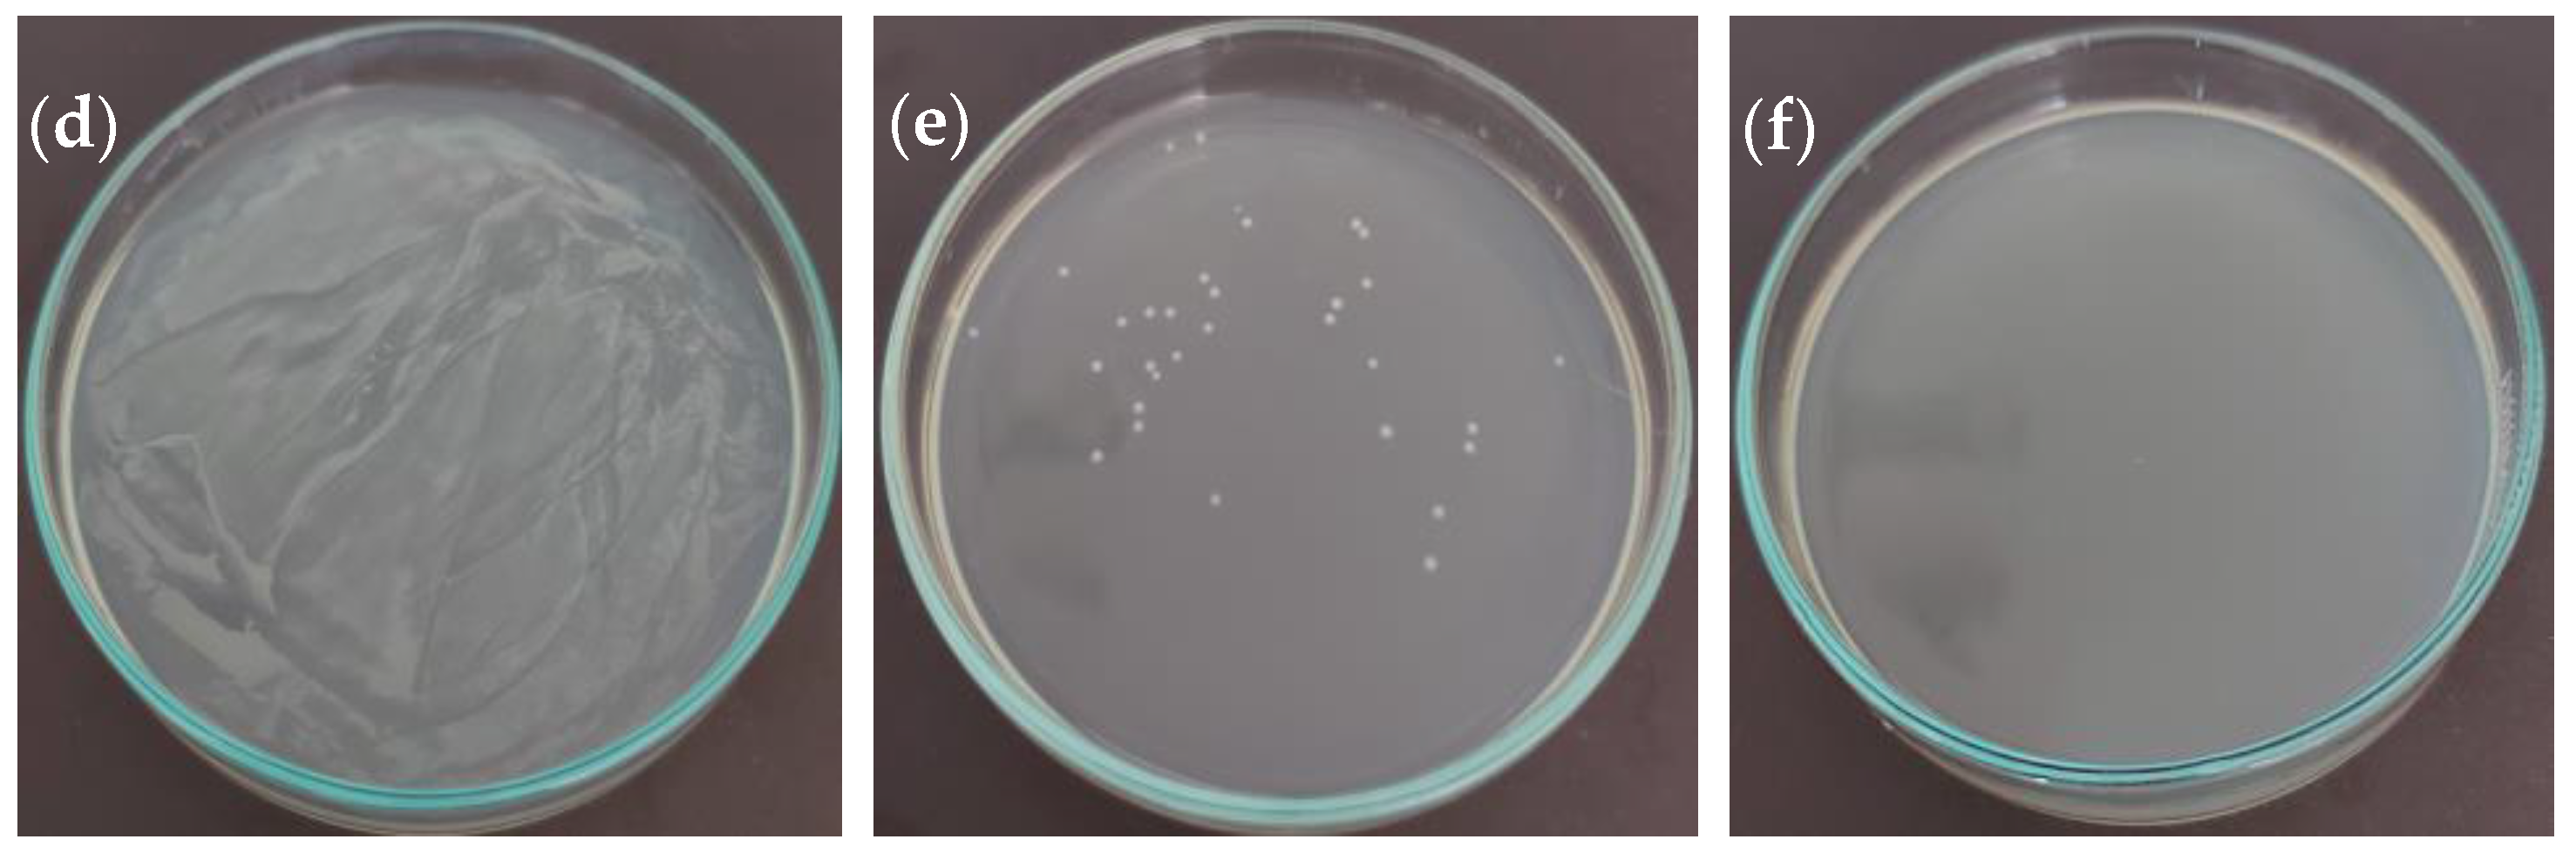

UHPLC-DAD Characterization of Origanum vulgare L. from Atacama Desert Andean Region and Antioxidant, Antibacterial and Enzyme Inhibition Activities
Abstract
1. Introduction
2. Results and Discussion
2.1. Chemical Composition
2.2. Chemical Constituents and Antioxidant Activity of Origanum vulgare L.
2.3. Antibacterial Activity
2.4. Enzyme Inhibitory Activity of Origanum vulgare L. Extract from ADAR
3. Materials and Methods
3.1. Plant Material
3.2. Extraction
3.3. Chemicals
3.4. Preparation of Standard Solutions
3.5. High-Performance Liquid Chromatography of Phenolic Compounds
3.6. Determination of Total Phenol and Flavonoid Contents
3.7. Antioxidant Activity Assays
3.7.1. Ferric Reducing Antioxidant Power (FRAP)
3.7.2. Free Radical Scavenging (DPPH)
3.7.3. ABTS Method
3.8. Antibacterial Activity
3.8.1. Strain and Growth Conditions
3.8.2. Minimum Inhibitory Concentration (MIC)
3.8.3. Minimum Bactericidal Concentration (MBC)
3.9. Inhibitory Effect on Metabolic Syndrome-Associated Enzymes
3.9.1. α-Amylase Inhibition Assay
3.9.2. α-Glucosidase Inhibition Assay
3.9.3. Lipase Inhibition Assay
3.10. Statistical Analysis
4. Conclusions
Author Contributions
Funding
Institutional Review Board Statement
Informed Consent Statement
Data Availability Statement
Acknowledgments
Conflicts of Interest
Sample Availability
References
- Rice-Evans, C.; Miller, N.; Paganga, G. Antioxidant properties of phenolic compounds. Trends Plant Sci. 1997, 2, 152–159. [Google Scholar] [CrossRef]
- Lang, G.; Buchbauer, G. A review on recent research results (2008–2010) on essential oils as antimicrobials and antifungals. A review. Flavour Fragr. J. 2011, 27, 13–39. [Google Scholar] [CrossRef]
- Sarikurkcu, C.; Zengin, G.; Oskay, M.; Uysal, S.; Ceylan, R.; Aktumsek, A. Composition, antioxidant, antimicrobial and enzyme inhibition activities of two Origanum vulgare subspecies (subsp. vulgare and subsp. hirtum) essential oils. Ind. Crops Prod. 2015, 70, 178–184. [Google Scholar] [CrossRef]
- Koldaş, S.; Demirtas, I.; Ozen, T.; Demirci, M.A.; Behçet, L. Phytochemical screening, anticancer and antioxidant activities of Origanum vulgare L. ssp. viride (Boiss.) Hayek, a plant of traditional usage. J. Sci. Food Agric. 2014, 95, 786–798. [Google Scholar] [CrossRef] [PubMed]
- Simirgiotis, M.J.; Burton, D.; Parra, F.; López, J.; Muñoz, P.; Escobar, H.; Parra, C. Antioxidant and Antibacterial Capacities of Origanum vulgare L. Essential Oil from the Arid Andean Region of Chile and its Chemical Characterization by GC-MS. Metabolites 2020, 10, 414. [Google Scholar] [CrossRef]
- Zhang, X.-L.; Guo, Y.-S.; Wang, C.-H.; Li, G.-Q.; Xu, J.-J.; Chung, H.Y.; Ye, W.-C.; Li, Y.-L.; Wang, G.-C. Phenolic compounds from Origanum vulgare and their antioxidant and antiviral activities. Food Chem. 2014, 152, 300–306. [Google Scholar] [CrossRef]
- Pezzani, R.; Vitalini, S.; Iriti, M. Bioactivities of Origanum vulgare L.: An update. Phytochem. Rev. 2017, 16, 1253–1268. [Google Scholar] [CrossRef]
- Elshafie, H.S.; Armentano, M.F.; Carmosino, M.; Bufo, S.A.; De Feo, V.; Camele, I. Cytotoxic Activity of Origanum vulgare L. on Hepatocellular Carcinoma cell Line HepG2 and Evaluation of its Biological Activity. Molecules 2017, 22, 1435. [Google Scholar] [CrossRef] [PubMed]
- Pandey, A.; Belwal, T.; Tamta, S.; Bhatt, I.D.; Rawal, R.S. Phenolic compounds, antioxidant capacity and antimutagenic activity in different growth stages of in vitro raised plants of Origanum vulgare L. Mol. Biol. Rep. 2019, 46, 2231–2241. [Google Scholar] [CrossRef] [PubMed]
- Sikander, M.; Malik, S.; Parveen, K.; Ahmad, M.; Yadav, D.; Bin Hafeez, Z.; Bansal, M. Hepatoprotective effect of Origanum vulgare in Wistar rats against carbon tetrachloride-induced hepatotoxicity. Protoplasma 2012, 250, 483–493. [Google Scholar] [CrossRef]
- Dimitrios, B. Sources of natural phenolic antioxidants. Trends Food Sci. Technol. 2006, 17, 505–512. [Google Scholar] [CrossRef]
- Havsteen, B.H. The biochemistry and medical significance of the flavonoids. Pharmacol. Ther. 2002, 96, 67–202. [Google Scholar] [CrossRef]
- Atanasov, A.G.; Waltenberger, B.; Pferschy-Wenzig, E.-M.; Linder, T.; Wawrosch, C.; Uhrin, P.; Temml, V.; Wang, L.; Schwaiger, S.; Heiss, E.H.; et al. Discovery and resupply of pharmacologically active plant-derived natural products: A review. Biotechnol. Adv. 2015, 33, 1582–1614. [Google Scholar] [CrossRef] [PubMed]
- Trevizan, J.; Soto, E.; Parra, F.; Bustos, L.; Parra, C. Antioxidant activity of nine medicinal plants with commercial potential. Idesia (Arica) 2020, 38, 53–58. [Google Scholar] [CrossRef]
- González, L.B.; Simirgiotis, M.J.; Parra, C.; Alfaro-Lira, S.; Soto, E.; Echiburú-Chau, C. In vitro screening for growth inhibition activity on cancer cell lines of northern Chile highlands shrubs. Ciência Rural 2021, 51. [Google Scholar] [CrossRef]
- Sik, B.; Kapcsándi, V.; Székelyhidi, R.; Hanczné, E.L.; Ajtony, Z. Recent Advances in the Analysis of Rosmarinic Acid From Herbs in the Lamiaceae Family. Nat. Prod. Commun. 2019, 14, 1934578X19864216. [Google Scholar] [CrossRef]
- Kakkar, S.; Bais, S. A Review on Protocatechuic Acid and Its Pharmacological Potential. ISRN Pharmacol. 2014, 2014, 952943. [Google Scholar] [CrossRef] [PubMed]
- Chou, T.-H.; Ding, H.-Y.; Lin, R.-J.; Liang, J.-Y.; Liang, C.-H. Inhibition of Melanogenesis and Oxidation by Protocatechuic Acid from Origanum vulgare (Oregano). J. Nat. Prod. 2010, 73, 1767–1774. [Google Scholar] [CrossRef] [PubMed]
- Abotaleb, M.; Liskova, A.; Kubatka, P.; Büsselberg, D. Therapeutic Potential of Plant Phenolic Acids in the Treatment of Cancer. Biomolecules 2020, 10, 221. [Google Scholar] [CrossRef]
- Bian, Q.; Gao, S.; Zhou, J.; Qin, J.; Taylor, A.; Johnson, E.J.; Tang, G.; Sparrow, J.R.; Gierhart, D.; Shang, F. Lutein and zeaxanthin supplementation reduces photooxidative damage and modulates the expression of inflammation-related genes in retinal pigment epithelial cells. Free Radic. Biol. Med. 2012, 53, 1298–1307. [Google Scholar] [CrossRef]
- Hayashi, R.; Hayashi, S.; Arai, K.; Sakai, M.; Okamoto, H.; Chikuda, M. The gender-differentiated antioxidant effects of a lutein-containing supplement in the aqueous humor of patients with senile cataracts. Exp. Eye Res. 2014, 129, 5–12. [Google Scholar] [CrossRef] [PubMed]
- Pasławska, M.; Sala, K.; Nawirska-Olszańska, A.; Stępień, B.; Pląskowska, E. Effect of Different Drying Techniques on Dehydration Kinetics, Physical Properties, and Chemical Composition of Lemon Thyme. Nat. Prod. Commun. 2020, 15, 1934578X20904521. [Google Scholar] [CrossRef]
- Kalisz, S.; Oszmiański, J.; Kolniak-Ostek, J.; Grobelna, A.; Kieliszek, M.; Cendrowski, A. Effect of a variety of polyphenols compounds and antioxidant properties of rhubarb (Rheum rhabarbarum). LWT 2020, 118, 108775. [Google Scholar] [CrossRef]
- Capecka, E.; Mareczek, A.; Leja, M. Antioxidant activity of fresh and dry herbs of some Lamiaceae species. Food Chem. 2005, 93, 223–226. [Google Scholar] [CrossRef]
- Georgieva, L.; Mihaylova, D. Screening of total phenolic content and radical scavenging capacity of Bulgarian plant species. Int. Food Res. J. 2015, 22, 240–245. [Google Scholar]
- Rahimmalek, M.; Afshari, M.; Sarfaraz, D.; Miroliaei, M. Using HPLC and multivariate analyses to investigate variations in the polyphenolic compounds as well as antioxidant and antiglycative activities of some Lamiaceae species native to Iran. Ind. Crops Prod. 2020, 154, 112640. [Google Scholar] [CrossRef]
- Tusevski, O.; Kostovska, A.; Iloska, A.; Trajkovska, L.; Simic, S. Phenolic production and antioxidant properties of some Macedonian medicinal plants. Open Life Sci. 2014, 9, 888–900. [Google Scholar] [CrossRef]
- Teixeira, B.; Marques, A.; Ramos, C.; Serrano, C.; Matos, O.; Neng, N.R.; Nogueira, J.M.F.; Saraiva, J.A.; Nunes, M.L. Chemical composition and bioactivity of different oregano (Origanum vulgare) extracts and essential oil. J. Sci. Food Agric. 2013, 93, 2707–2714. [Google Scholar] [CrossRef] [PubMed]
- SSimirgiotis, M.J.; Benites, J.; Areche, C.; Sepúlveda, B. Antioxidant Capacities and Analysis of Phenolic Compounds in Three Endemic Nolana Species by HPLC-PDA-ESI-MS. Molecules 2015, 20, 11490–11507. [Google Scholar] [CrossRef]
- Cho, W.-I.; Chung, M.-S. Bacillus spores: A review of their properties and inactivation processing technologies. Food Sci. Biotechnol. 2020, 29, 1447–1461. [Google Scholar] [CrossRef]
- Olila, D.; Opuda-Asibo, J. Antibacterial and antifungal activities of extracts of Zanthoxylum chalybeum and Warburgia ugandensis, Ugandan medicinal plants. Afr. Health Sci. 2001, 1, 66–72. [Google Scholar] [PubMed]
- Lehtopolku, M.; Kotilainen, P.; Puukka, P.; Nakari, U.-M.; Siitonen, A.; Eerola, E.; Huovinen, P.; Hakanen, A.J. Inaccuracy of the Disk Diffusion Method Compared with the Agar Dilution Method for Susceptibility Testing of Campylobacter spp. J. Clin. Microbiol. 2011, 50, 52–56. [Google Scholar] [CrossRef] [PubMed]
- Abedini, A.; Roumy, V.; Mahieux, S.; Biabiany, M.; Standaert-Vitse, A.; Rivière, C.; Sahpaz, S.; Bailleul, F.; Neut, C.; Hennebelle, T. Rosmarinic Acid and Its Methyl Ester as Antimicrobial Components of the Hydromethanolic Extract of Hyptis atrorubens Poit. (Lamiaceae). Evid. Based Complement. Altern. Med. 2013, 2013, 604536. [Google Scholar] [CrossRef] [PubMed]
- Souza, E.; Stamford, T.; Lima, E.; Trajano, V. Effectiveness of Origanum vulgare L. essential oil to inhibit the growth of food spoiling yeasts. Food Control 2007, 18, 409–413. [Google Scholar] [CrossRef]
- Ghani, U. Re-exploring promising α-glucosidase inhibitors for potential development into oral anti-diabetic drugs: Finding needle in the haystack. Eur. J. Med. Chem. 2015, 103, 133–162. [Google Scholar] [CrossRef] [PubMed]
- Dong, H.-Q.; Li, M.; Zhu, F.; Liu, F.-L.; Huang, J.-B. Inhibitory potential of trilobatin from Lithocarpus polystachyus Rehd against α-glucosidase and α-amylase linked to type 2 diabetes. Food Chem. 2012, 130, 261–266. [Google Scholar] [CrossRef]
- Khan, M.; Liu, H.; Wang, J.; Sun, B. Inhibitory effect of phenolic compounds and plant extracts on the formation of advance glycation end products: A comprehensive review. Food Res. Int. 2020, 130, 108933. [Google Scholar] [CrossRef]
- Henness, S.; Perry, C.M. Orlistat. Drugs 2006, 66, 1625–1656. [Google Scholar] [CrossRef]
- Picot, M.C.N.; Mahomoodally, M.F. Effects of Aphloia theiformis on key enzymes related to diabetes mellitus. Pharm. Biol. 2017, 55, 864–872. [Google Scholar] [CrossRef] [PubMed]
- McCue, P.P.; Shetty, K. Inhibitory effects of rosmarinic acid extracts on porcine pancreatic amylase in vitro. Asia Pac. J. Clin. Nutr. 2004, 13, 101–106. [Google Scholar] [PubMed]
- Funke, I.; Melzig, M. Effect of different phenolic compounds on α-amylase activity: Screening by microplate-reader based kinetic assay. Die Pharm. Int. J. Pharm. Sci. 2005, 60, 796–797. [Google Scholar]
- Eddouks, M.; Maghrani, M.; Lemhadri, A.; Ouahidi, M.-L.; Jouad, H. Ethnopharmacological survey of medicinal plants used for the treatment of diabetes mellitus, hypertension and cardiac diseases in the south-east region of Morocco (Tafilalet). J. Ethnopharmacol. 2002, 82, 97–103. [Google Scholar] [CrossRef]
- Kwon, Y.-I.I.; Vattem, D.A.; Shetty, K. Evaluation of clonal herbs of Lamiaceae species for management of diabetes and hypertension. Asia Pac. J. Clin. Nutr. 2006, 15, 107–118. [Google Scholar] [PubMed]
- Oboh, G.; Ogunsuyi, O.B.; Ogunbadejo, M.D.; Adefegha, S.A. Influence of gallic acid on α-amylase and α-glucosidase inhibitory properties of acarbose. J. Food Drug Anal. 2016, 24, 627–634. [Google Scholar] [CrossRef] [PubMed]
- Soto, E.; Bustos, L.; Simirgiotis, M.J.; Parra, C. Potential of Baccharis alnifolia Meyen & Walpan (Chilka) from northern Chile used as a medicinal infusion. Ciência Rural 2019, 49. [Google Scholar] [CrossRef]
- Parra, C.; Soto, E.; León, G.; Salas, C.O.; Heinrich, M.; Echiburú-Chau, C. Nutritional composition, antioxidant activity and isolation of scopoletin from Senecio nutans: Support of ancestral and new uses. Nat. Prod. Res. 2017, 32, 719–722. [Google Scholar] [CrossRef] [PubMed]
- Echiburú-Chau, C.; Pasten, L.; Parra, C.; Bórquez, J.; Mocan, A.; Simirgiotis, M.J. High resolution UHPLC-MS characterization and isolation of main compounds from the antioxidant medicinal plant Parastrephia lucida (Meyen). Saudi Pharm. J. 2017, 25, 1032–1039. [Google Scholar] [CrossRef] [PubMed]
- Burgos-Edwards, A.; Jiménez-Aspee, F.; Thomas-Valdés, S.; Schmeda-Hirschmann, G.; Theoduloz, C. Qualitative and quantitative changes in polyphenol composition and bioactivity of Ribes magellanicum and R. punctatum after in vitro gastrointestinal digestion. Food Chem. 2017, 237, 1073–1082. [Google Scholar] [CrossRef] [PubMed]

| Peak | Phenolic Compounds | RT | OV ADAR * |
|---|---|---|---|
| 1 | Gallic acid | 2.62 | 43.60 ± 2.91 |
| 2 | Protocatechuic acid | 2.70 | 61.99 ± 3.55 |
| 4 | (−)-epigallocatechin | 3.68 | 4.09 ± 0.04 |
| 5 | (+)-catechin | 4.07 | 2.92 ± 2.14 |
| 6 | 4-hydroxybenzoic acid | 4.17 | 9.99 ± 1.07 |
| 8 | Chlorogenic acid | 4.67 | 2.55 ± 0.67 |
| 10 | Vanillic acid | 4.97 | 5.45 ± 0.66 |
| 11 | Caffeic acid | 5.08 | 4.85 ± 0.26 |
| 12 | Rosmarinic acid | 5.23 | 76.01 ± 2.01 |
| 13 | p-Coumaric acid | 5.78 | 9.32 ± 0.06 |
| 14 | Ferulic acid | 6.13 | 11.72 ± 0.19 |
| 15 | Rutin | 6.65 | 18.01 ± 2.41 |
| 16 | Sinapic acid | 7.47 | 3.29 ± 0.36 |
| 18 | trans-cinnamic acid | 8.92 | 3.82 ± 0.81 |
| 19 | Luteolin | 9.23 | 27.31 ± 2.13 |
| 20 | Naringenin | 11.12 | 24.32 ± 1.15 |
| 23 | Apigenin | 13.35 | 5.81 ± 0.57 |
| 24 | Kaempferol | 13.85 | 5.76 ± 1.24 |
| 27 | Carvacrol | 16.60 | 1.16 ± 1.01 |
| 28 | Thymol | 17.08 | 8.10 ± 2.52 |
| Phenolic acids and their derivatives | 232.59 ± 12.55 | ||
| Flavonoids | 88.22 ± 9.68 | ||
| Phenolic monoterpenes | 9.26 ± 3.53 | ||
| Species | DPPH | ABTS | FRAP | TPC | TFC |
|---|---|---|---|---|---|
| (µg/mL) | (µmol TE/100 g DW) | (mg GAE/100 g DW) | (mg QE/100 g DW) | ||
| OV ADAR | 40.58 ± 5.41 a | 8266 ± 251.50 | 5156 ± 163.26 | 3948 ± 40.17 | 593 ± 30.50 |
| Quercetin * | 6.99 ± 0.02 b | - | - | - | - |
| Trolox * | 20.99 ± 1.24 c | - | - | - | - |
| Bacteria | MIC 1 (mg/mL) | MIC Kan 2 (µg/mL) | MBC 3 (mg/mL) | MBC Kan 4 (µg/mL) |
|---|---|---|---|---|
| Escherichia coli (ATCC 23716) | 0.156 | 5.00 | 2.50 | 10.00 |
| Pseudomonas aeruginosa (ATCC 19429) | 0.156 | 5.00 | 1.25 | 10.00 |
| Salmonella enterica (ATCC 13311) | 0.078 | 2.50 | 1.25 | 5.00 |
| Bacillus subtilis (ATCC 6051) | 0.156 | 1.25 | ND | 20.00 |
| Staphylococcus aureus (ATCC 29737) | 0.156 | 2.50 | 1.25 | 10.00 |
| Erwinia rhapontici (MK883065) | 0.313 | 1.25 | 2.50 | 2.50 |
| Pseudomonas syringae (MF547632) | 0.313 | 1.25 | 1.25 | 2.50 |
| Pantoea agglomerans (MK883087) | 0.313 | 2.50 | 1.25 | 5.00 |
| Agrobacterium tumefaciens (ATCC 19358) | 0.625 | 1.25 | 5.00 | 5.00 |
| Xanthomonas campestris (MH885473) | ND | 2.50 | ND | 10.00 |
| Sample | α-Amylase (IC50 µg/mL) | α-Glucosidase (IC50 µg/mL) | Pancreatic Lipase (IC50 µg/mL) |
|---|---|---|---|
| OV ADAR | 44.71 ± 0.86 a | 7.11 ± 1.37 a | 922.35 ± 30.99 a |
| Acarbose * | 29.49 ± 0.94 b | 129.32 ± 1.52 b | - |
| Orlistat® * | - | - | 40.83 ± 3.04 b |
Publisher’s Note: MDPI stays neutral with regard to jurisdictional claims in published maps and institutional affiliations. |
© 2021 by the authors. Licensee MDPI, Basel, Switzerland. This article is an open access article distributed under the terms and conditions of the Creative Commons Attribution (CC BY) license (https://creativecommons.org/licenses/by/4.0/).
Share and Cite
Parra, C.; Muñoz, P.; Bustos, L.; Parra, F.; Simirgiotis, M.J.; Escobar, H. UHPLC-DAD Characterization of Origanum vulgare L. from Atacama Desert Andean Region and Antioxidant, Antibacterial and Enzyme Inhibition Activities. Molecules 2021, 26, 2100. https://doi.org/10.3390/molecules26072100
Parra C, Muñoz P, Bustos L, Parra F, Simirgiotis MJ, Escobar H. UHPLC-DAD Characterization of Origanum vulgare L. from Atacama Desert Andean Region and Antioxidant, Antibacterial and Enzyme Inhibition Activities. Molecules. 2021; 26(7):2100. https://doi.org/10.3390/molecules26072100
Chicago/Turabian StyleParra, Claudio, Patricio Muñoz, Luis Bustos, Felipe Parra, Mario J. Simirgiotis, and Hugo Escobar. 2021. "UHPLC-DAD Characterization of Origanum vulgare L. from Atacama Desert Andean Region and Antioxidant, Antibacterial and Enzyme Inhibition Activities" Molecules 26, no. 7: 2100. https://doi.org/10.3390/molecules26072100
APA StyleParra, C., Muñoz, P., Bustos, L., Parra, F., Simirgiotis, M. J., & Escobar, H. (2021). UHPLC-DAD Characterization of Origanum vulgare L. from Atacama Desert Andean Region and Antioxidant, Antibacterial and Enzyme Inhibition Activities. Molecules, 26(7), 2100. https://doi.org/10.3390/molecules26072100

